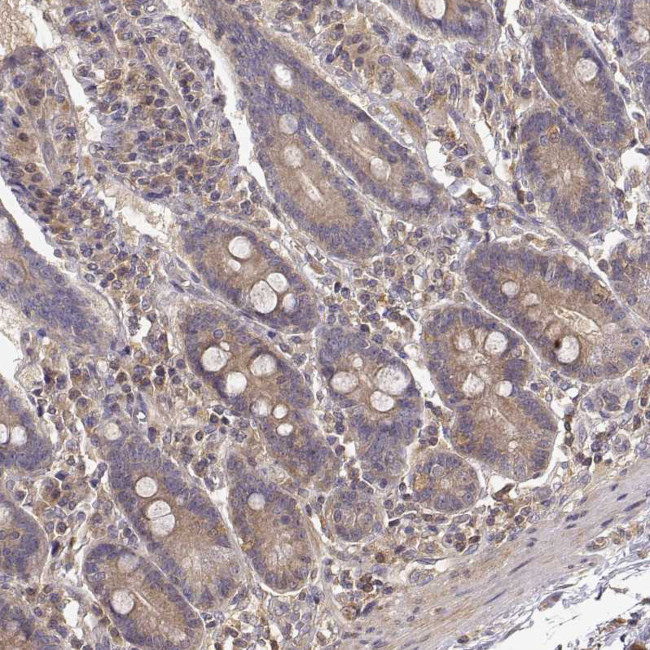
CRIM1 Antibody in Immunohistochemistry (Paraffin) (IHC (P))

Search
Invitrogen
CRIM1 Polyclonal Antibody
{{$productOrderCtrl.translations['antibody.pdp.commerceCard.promotion.promotions']}}
{{$productOrderCtrl.translations['antibody.pdp.commerceCard.promotion.viewpromo']}}
{{$productOrderCtrl.translations['antibody.pdp.commerceCard.promotion.promocode']}}: {{promo.promoCode}} {{promo.promoTitle}} {{promo.promoDescription}}. {{$productOrderCtrl.translations['antibody.pdp.commerceCard.promotion.learnmore']}}
产品信息
PA5-51412
种属反应
宿主/亚型
分类
类型
抗原
偶联物
形式
浓度
规格
纯化类型
保存液
内含物
保存条件
运输条件
RRID
产品详细信息
Immunogen sequence: LTEYEAGVCE DENWTDDQLL GFKPCNENLI AGCNIINGKC ECNTIRTCSN PFEFPSQDMC LSALKRIEEE KPDCSKARCE VQFSPRCPED SVLIEGYAPP GECCPLP
Highest antigen sequence identity to the following orthologs: Mouse - 88%, Rat - 88%.
靶标信息
CRIM1 (cysteine-rich motor neuron 1), a glycosylated type I transmembrane protein, plays a role in tissue development i.e. capillary formation and maintenance during angiogenesis. It contains an N-terminal IGF-binding protein-like motif and six von Willebrand-like cysteine-rich repeats (CRRs) in its extracellular domain. CRIM1 interacts with BMP4 and BMP7 via the CRRs and functions as an antagonist. CRIM1 is developmentally expressed in a number of tissues including the pancreas, kidney, placenta, brain and blood vessels. CRIM1 may participate in CNS and placental development by interacting with growth factors involved in motor neuron differentiation and survival.
仅用于科研。不用于诊断过程。未经明确授权不得转售。
篇参考文献 (0)
生物信息学
蛋白别名: CRIM-1; cysteine rich transmembrane BMP regulator 1 (chordin-like); Cysteine-rich motor neuron 1 protein; Cysteine-rich repeat-containing protein S52; similar to thrombospondin, sog and chd; unnamed protein product
基因别名: CRIM-1; CRIM1; S52; UNQ1886/PRO4330
UniProt ID: (Human) Q9NZV1
Entrez Gene ID: (Human) 51232